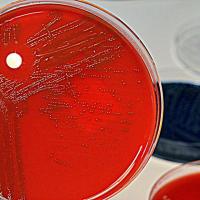

Articolo
Sono ancora troppo pochi i malati rari che hanno preso parte ad almeno un progetto di ricerca nella loro vita. Solo il 37%, di cui il 18% per sviluppo di nuove terapie e il 15% per indagini sulla qualità della vita.
È quanto ha recentemente sottolineato il direttore generale dell’Agenzia Italiana del Farmaco (AIFA), Mario Melazzini.
«Si rilevano... Continua
Articolo
Le cure della mamma possono modificare il DNA: esperimenti sui topi mostrano che nel cervello dei cuccioli più trascurati dalle madri si accumula un maggior numero di copie di geni “ballerini”, in grado di replicarsi e spostarsi da un punto all'altro del genoma. La scoperta potrebbe aiutare a comprendere, nell'uomo, le cause di disturbi come... Continua
Articolo
Preparazione: 40 minuti - Cottura: 15 minuti
Ingredienti
(dose per ventiquattro biscotti)
- 2 banane piccole (100 g circa)
- 80 g di farina di lupini
- 80 g di farina d’avena (in caso di celiachia certificata senza glutine - se non trovate la farina d’avena certificata, potete utilizzare fiocchi d’avena certificati e tritarli con un robot da... Continua
Articolo
Dall'analisi di una sola goccia di sangue diventa possibile diagnosticare la setticemia, la pericolosa reazione immunitaria dovuta a una grave infezione estesa a tutto l'organismo. Descritto sulla rivista Nature Biomedical Engineering, il test è economico e rapido, in quanto dà risposte in poche ore, ed è stato sviluppato da Daniel Irimia, del... Continua
Articolo
Una rete di laboratori a cielo aperto in tutta Italia per produrre frutta e verdura biologica sempre più amici dell'ambiente, ma anche del portafoglio, per fare in modo di abbassare i costi di produzione e quindi nello scaffale per il consumatore finale. La ricerca scommette così sull'agricoltura bio, con un percorso al passo con i tempi... Continua
Articolo
Due anziani colpiti da degenerazione maculare legata all'età hanno recuperato la vista grazie ad una terapia innovativa con le staminali embrionali provata per la prima volta. In uno dei due occhi gli è stato impiantato un “cerotto vivente” fatto con le cellule del tessuto della retina, ricavate dalle staminali. La terapia sperimentale, testata al... Continua
Articolo
Un quarto dei farmaci usati comunemente ha un effetto negativo sui batteri che vivono nell'intestino (microbioma intestinale) paragonabile a quello degli antibiotici.
Lo ha scoperto uno studio europeo pubblicato dalla rivista Nature, secondo cui questo può avere un effetto anche sul fenomeno della resistenza.
I ricercatori del Laboratorio Europeo... Continua
Articolo
È in media di 65 giorni l'attesa per una visita nella sanità pubblica, contro 7 giorni nel privato e 6 in intramoenia.
Emerge dall'Osservatorio sui tempi di attesa e sui costi delle prestazioni sanitarie nei Sistemi Sanitari Regionali, ricerca commissionata dalla Funzione Pubblica CGIL e condotta dal centro C.R.E.A. Sanità. È la prima indagine a... Continua
Articolo
I pazienti lo descrivono come “uno spillone infuocato infilato nell'occhio”, una “agonia”. Responsabile è la cefalea a grappolo, una patologia che pur rientrando tra le cefalee primarie non ha niente a che vedere con un comune mal di testa. Le conseguenze sono devastanti in famiglia e sul lavoro, non esistono possibilità di prevenzione e anche i... Continua
Articolo
Era agosto quando pubblicammo sul nostro giornale un articolo, assai letto e condiviso, sulla plasmaferesi (vedi Lavaggio del sangue: una terapia utile per guarire da più di ottanta malattie).
Decine le domande e i commenti di Voi lettori e a distanza di mesi, raccogliendo tutto questo materiale, abbiamo deciso di interpellare nuovamente la... Continua
Tipo
Categoria
- Salute (1245) Apply Salute filter
- Ambiente (798) Apply Ambiente filter
- Sociale (612) Apply Sociale filter
- Cultura (245) Apply Cultura filter
- A Tavola (101) Apply A Tavola filter
- Curiosità (84) Apply Curiosità filter
- Focus su A.D.A.S. (21) Apply Focus su A.D.A.S. filter
- Storie di Sicilia (10) Apply Storie di Sicilia filter
autore
- redazione (2668) Apply redazione filter
- Federica Campilongo (75) Apply Federica Campilongo filter
- Andrea Cuscona (72) Apply Andrea Cuscona filter
- Marisa Falcone (58) Apply Marisa Falcone filter
- Federico Bizzini (48) Apply Federico Bizzini filter
- Santo Gulisano (33) Apply Santo Gulisano filter
- Jose Marano (32) Apply Jose Marano filter
- Chezia Alberti (26) Apply Chezia Alberti filter
- Santi Maria Randazzo (26) Apply Santi Maria Randazzo filter
- Guido Bissanti (21) Apply Guido Bissanti filter
- Benedetto Rizzo (15) Apply Benedetto Rizzo filter
- Francesca Santangelo (15) Apply Francesca Santangelo filter
- Riccardo Anastasi (15) Apply Riccardo Anastasi filter
- Sabrina Portale (15) Apply Sabrina Portale filter
- Silvana Militello (15) Apply Silvana Militello filter
- Antonio Percolla (12) Apply Antonio Percolla filter
- Sarah Donzuso (12) Apply Sarah Donzuso filter
- Tiziano Fusella (12) Apply Tiziano Fusella filter
- Anna Arietti (11) Apply Anna Arietti filter
- Julia Karpova (9) Apply Julia Karpova filter
- Mario Guarnera (8) Apply Mario Guarnera filter
- Luca Talamona (7) Apply Luca Talamona filter
- Dino Artale (6) Apply Dino Artale filter
- Raffaella Sacco (6) Apply Raffaella Sacco filter
- Valerio Gullotta (6) Apply Valerio Gullotta filter
- Andrea Maglia (5) Apply Andrea Maglia filter
- Angela Longo (5) Apply Angela Longo filter
- Barbara Corbellini (5) Apply Barbara Corbellini filter
- Maria Rita Ursino (5) Apply Maria Rita Ursino filter
- Paolo Reitano (5) Apply Paolo Reitano filter
- Ramona Tafuri (5) Apply Ramona Tafuri filter
- Antonio Andolfi (4) Apply Antonio Andolfi filter
- Caterina Lenti (4) Apply Caterina Lenti filter
- Cetty Moscatt (4) Apply Cetty Moscatt filter
- Davide Di Paola (4) Apply Davide Di Paola filter
- Enzo Faraone (4) Apply Enzo Faraone filter
- Francesca Romana Golino (4) Apply Francesca Romana Golino filter
- Giulia Leotta (4) Apply Giulia Leotta filter
- Michelle Recupero (4) Apply Michelle Recupero filter
- Adriana Alberghina (3) Apply Adriana Alberghina filter
- Agata Damante (3) Apply Agata Damante filter
- Alessia Costanzo (3) Apply Alessia Costanzo filter
- Angela Strano (3) Apply Angela Strano filter
- Giulia Faraone (3) Apply Giulia Faraone filter
- Serena Bonaccorsi (3) Apply Serena Bonaccorsi filter
- Steven Giuffrida (3) Apply Steven Giuffrida filter
- Federica Catalano (2) Apply Federica Catalano filter
- Gaetano Lo Monaco e Angela Longo (2) Apply Gaetano Lo Monaco e Angela Longo filter
- Salvina Favara (2) Apply Salvina Favara filter
- Vittoria Averni (2) Apply Vittoria Averni filter